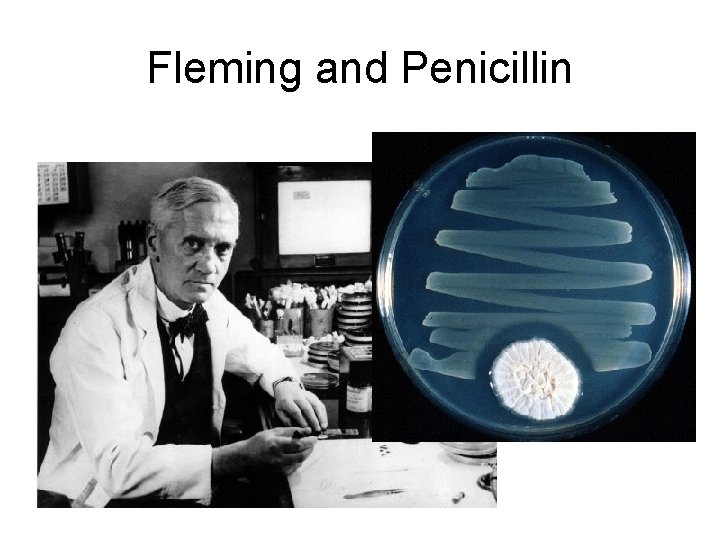
Fleming and Penicillin  Fleming and Penicillin

Antimicrobial Drugs Fading Miracle Ehrlichs Magic Bullets Fleming


Antimicrobial Drugs Fading Miracle?

Ehrlich’s Magic Bullets
Fleming and Penicillin

Chemotherapy • The use of drugs to treat a disease • Selective toxicity: A drug that kills harmful microbes without damaging the host

Antibiotic/Antimicrobial • Antibiotic: Chemical produced by a microorganism that kills or inhibits the growth of another microorganism • Antimicrobial agent: Chemical that kills or inhibits the growth of microorganisms

Microbial Sources of Antibiotics

Antibiotic Spectrum of Activity • No antibiotic is effective against all microbes

Mechanisms of Antimicrobial Action • Bacteria have their own enzymes for – Cell wall formation – Protein synthesis – DNA replication – RNA synthesis – Synthesis of essential metabolites

Mechanisms of Antimicrobial Action • Viruses use host enzymes inside host cells • Fungi and protozoa have own eukaryotic enzymes • The more similar the pathogen and host enzymes, the more side effects the antimicrobials will have

Modes of Antimicrobial Action

Antibacterial Antibiotics Inhibitors of Cell Wall Synthesis • Penicillin (over 50 compounds) – Share 4 -sided ring ( lactam ring) • Natural penicillins • Narrow range of action • Susceptible to penicillinase ( lactamase)

Prokaryotic Cell Walls

Penicillins Fig 20. 6 Figure 20. 6

Penicillinase ( Lactamase) Figure 20. 8

Semisynthetic Penicillins • Penicilinase-resistant penicillins • Carbapenems: very broad spectrum • Monobactam: Gram negative • Extended-spectrum penicillins • Penicillins + -lactamase inhibitors

Other Inhibitors of Cell Wall Synthesis • Cephalosporins – 2 nd, 3 rd, and 4 th generations more effective against gram-negatives Figure 20. 9

Other Inhibitors of Cell Wall Synthesis • Polypeptide antibiotics – Bacitracin • Topical application • Against gram-positives – Vancomycin • Glycopeptide • Important "last line" against antibiotic resistant S. aureus

Other Inhibitors of Cell Wall Synthesis • Antibiotics effective against Mycobacteria: interfere with mycolic acid synthesis or incorporation – Isoniazid (INH) – Ethambutol

Inhibitors of Protein Synthesis • Broad spectrum, toxicity problems • Examples – Chloramphenicol (bone marrow) – Aminoglycosides: Streptomycin, neomycin, gentamycin (hearing, kidneys) – Tetracyclines (Rickettsias & Chlamydia; GI tract) – Macrolides: Erythromycin (gram +, used in children)

Injury to the Plasma Membrane • Polymyxin B (Gram negatives) – Topical – Combined with bacitracin and neomycin (broad spectrum) in over-the-counter preparation

Inhibitors of Nucleic Acid Synthesis • Rifamycin – Inhibits RNA synthesis – Antituberculosis • Quinolones and fluoroquinolones – Ciprofloxacin – Inhibits DNA gyrase – Urinary tract infections

Competitive Inhibitors – Sulfonamides (Sulfa drugs) • Inhibit folic acid synthesis • Broad spectrum Figure 5. 7

Antifungal Drugs • Fungi are eukaryotes • Have unique sterols in their cell walls • Pathogenic fungi are often outside the body

Antiviral Drugs • Viruses are composed of nucleic acid, protein capsid, and host membrane containing virus proteins • Viruses live inside host cells and use many host enzymes • Some viruses have unique enzymes for DNA/RNA synthesis or protein cutting in virus assembly Figure 20. 16 a

Antiviral Drugs Nucleoside and Nucleotide Analogs Figure 20. 16 a

Analogs Block DNA Synthesis Figure 20. 16 b, c

Antiviral Drugs Enzyme Inhibitors • Inhibit assembly – Indinavir (HIV) • Inhibit attachment – Zanamivir (Influenza) • Inhibit uncoating – Amantadine (Influenza)

Antiviral Drugs Enzyme Inhibitors • Interferons prevent spread of viruses to new cells (Viral hepatitis) • Natural products of the immune system in viral infections

Antiprotozoan Drugs • Protozoa are eukaryotic cells • Many drugs are experimental and their mode of action is unknown

Antihelminthic Drugs • Helminths are macroscopic multicellular eukaryotic organisms: tapeworms, roundworms, pinworms, hookworms

Antihelminthic Drugs • Prevent ATP generation (Tapeworms) • Alters membrane permeability (Flatworms) • Neuromuscular block (Intestinal roundworms) • Inhibits nutrient absorption (Intestinal roundworms) • Paralyzes worm (Intestinal roundworms)

Measuring Antimicrobial Sensitivity • E Test • MIC: Minimal inhibitory concentration

Measuring Antimicrobial Sensitivity: Disk Diffusion

Antibiotic Resistance Figure 20. 20

Antimicrobial Resistance • Relative or complete lack of effect of antimicrobial against a previously susceptible microbe • Increase in MIC

Mechanisms of Antibiotic Resistance • • Enzymatic destruction of drug Prevention of penetration of drug Alteration of drug's target site Rapid ejection of the drug

Antibiotic Selection for Resistant Bacteria

What Factors Promote Antimicrobial Resistance? • Exposure to sub-optimal levels of antimicrobial • Exposure to microbes carrying resistance genes

Inappropriate Antimicrobial Use • Prescription not taken correctly • Antibiotics for viral infections • Antibiotics sold without medical supervision • Spread of resistant microbes in hospitals due to lack of hygiene

Inappropriate Antimicrobial Use • Lack of quality control in manufacture or outdated antimicrobial • Inadequate surveillance or defective susceptibility assays • Poverty or war • Use of antibiotics in foods

Antibiotics in Foods • Antibiotics are used in animal feeds and sprayed on plants to prevent infection and promote growth • Multi drug-resistant Salmonella typhi has been found in 4 states in 18 people who ate beef fed antibiotics

Consequences of Antimicrobial Resistance • Infections resistant to available antibiotics • Increased cost of treatment


Multi-Drug Resistant TB

MRSA “mer-sah” • Methicillin-Resistant Staphylococcus aureus • Most frequent nosocomial (hospitalacquired) pathogen • Usually resistant to several other antibiotics

Vancomycin Resistant Enterococci

Vancomycin Use USA

Proposals to Combat Antimicrobial Resistance • • Speed development of new antibiotics Track resistance data nationwide Restrict antimicrobial use Direct observed dosing (TB)

Proposals to Combat Antimicrobial Resistance • Use more narrow spectrum antibiotics • Use antimicrobial cocktails

The Future of Chemotherapeutic Agents • Antimicrobial peptides – Broad spectrum antibiotics from plants and animals • Squalamine (sharks) • Protegrin (pigs) • Magainin (frogs)

The Future of Chemotherapeutic Agents • Antisense agents – Complementary DNA or peptide nucleic acids that binds to a pathogen's virulence gene(s) and prevents transcription
- Slides: 52